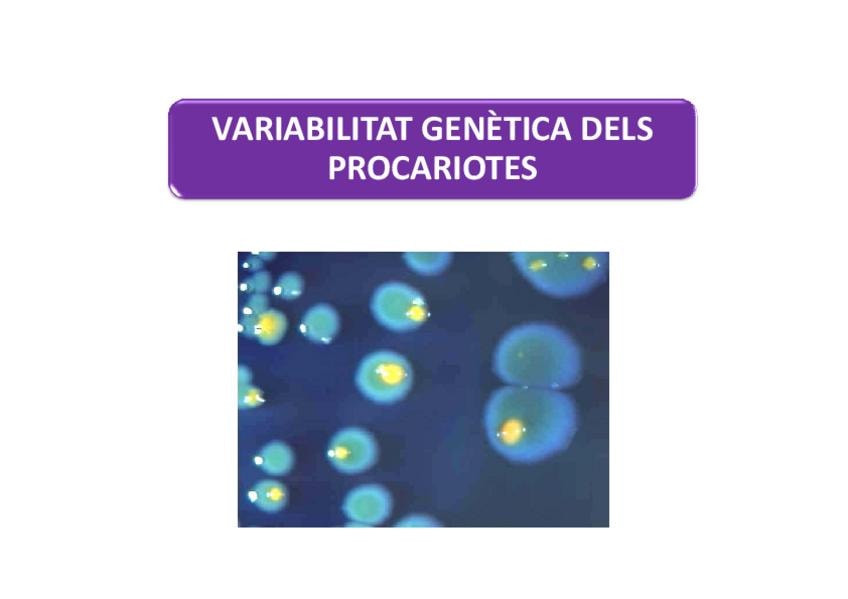

Bloc 1. El mon microbia.pdf
8 páginas

Bloc 1. Tècniques.pdf
8 páginas

Bloc 2. Composicio i estructura celular.pdf
8 páginas

Bloc 2. Contingut citoplasmatic.pdf
8 páginas

Bloc 2. Elements extracelulars i moviments.pdf
8 páginas

Bloc 2. Membrana plasmatica.pdf
8 páginas

Bloc 2. Paret bacteriana.pdf
7 páginas

BLOC 3. Anabolisme.pdf
8 páginas

BLOC 3. Metabolisme aerobi dels quimioorganotrofs.pdf
8 páginas

BLOC 3. Metabolisme anaerobi dels quimioorganotrofs.pdf
7 páginas

BLOC 3. Metabolisme dels procariotes.pdf
7 páginas

BLOC 3. Metabolisme fototrof.pdf
7 páginas

BLOC 3. Metabolisme quimiolitotrof.pdf
7 páginas

BLOC 4. Control del creixement microbià.pdf
7 páginas
BLOC 4. Creixement microbià.pdf
11 páginas

BLOC 5. Genètica de procariotes (ppw).pdf
7 páginas

BLOC 5. Variabilitat genètica de procariotes (ppw).pdf
11 páginas

BLOC 6. Infeccions víriques.pdf
7 páginas

BLOC 6. Naturalesa dels virus.pdf
7 páginas

BLOC 7. No proteobacteris.pdf
7 páginas

BLOC 7. Eucariotes.pdf
11 páginas

BLOC 7. Gram-positius.pdf
11 páginas

BLOC 7. Proteobacteris.pdf
11 páginas

BLOC 7. Taxonomia.pdf
1 página

MICROBIOLOGIA-questionari.pdf
11 páginas

MICROBIOLOGIA-questionari-SOLUCIONS-1.pdf
1 página

Taxonomia.pdf
16 páginas